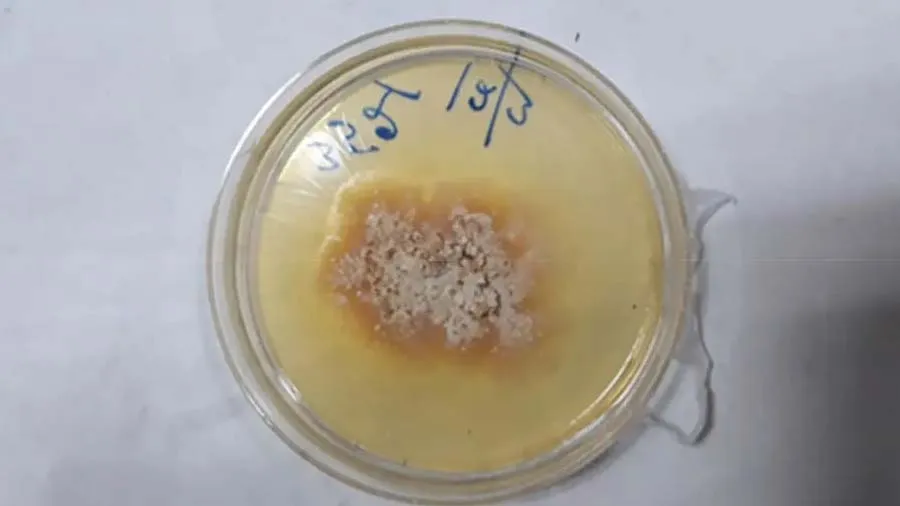

- National
- છોડથી સંક્રમિત થયો વ્યક્તિ, દુનિયાનો એવો પહેલો કેસ, જાણો શું હોય છે આ બીમારી
છોડથી સંક્રમિત થયો વ્યક્તિ, દુનિયાનો એવો પહેલો કેસ, જાણો શું હોય છે આ બીમારી
પશ્ચિમ બંગાળના કોલકાતામાં એક એવી બીમારી બાબતે જાણકારી મળી છે, જેમાં એક છોડથી એક વ્યક્તિ સંક્રમિત થઈ ગયો હતો. આ બીમારીનું નામ કીલર પ્લાન્ટ ફંગલ છે, જે છોડમાંથી માણસમાં ફેલાય છે. કોલકાતામાં આવેલો આ કેસ પોતાની જાતનમાં દુનિયાનો પહેલો કેસ હોવાનું કહેવામાં આવી રહ્યું છે. રિપોર્ટ્સ મુજબ, 61 વર્ષીય જે વ્યક્તિને લઈને કીલર પ્લાન્ટ ફંગસ નામની આ બીમારી થઈ હતી. વ્યવસાયી પ્લાન્ટ માઇક્રોલોજિસ્ટ છે. માઇક્રોલોજિસ્ટ તરીકે કામ કરતા તે સડનારી સામગ્રી, મશરૂમ અને અલગ અલગ છોડના ફંગલ પર રિસર્ચ કરતી વખત વિતાવતો રહ્યો.

બીમારીના લક્ષણોની વાત કરીએ તો સંક્રમિત દર્દીના અવાજમાં બદલાવ આવી ગયો અને તેને ખાવામાં ખૂબ પરેશાનીનો સામનો કરવો પડ્યો હતો. તબિયત વધારે ખરાબ થયા બાદ તેને કોલકાતાની એક હૉસ્પિટલમાં દાખલ કરાવવામાં આવ્યો છે, જ્યાં તેની સારવાર કરવામાં આવી હતી. તેની સારવાર કરનારા ડૉક્ટર્સ મુજબ, દર્દીને છેલ્લા 3 મહિનાથી ખાંસી, થાક અને ખાવાનું ગળવામાં સમસ્યા થઈ રહી હતી. તેના કારણે તેનો અવાજ પણ બદલાઈ ગયો હતો.

સીટી સ્કેન કરવા પર તેના ગળામાં એક પેરાટ્રાચેયલ ફોલ્લી નજરે પડી. તપાસ બાદ ડૉક્ટર્સે એ ફોલ્લી હટાવી દીધી અને ટેસ્ટ માટે એક સેમ્પલ, વિશ્વ આરોગ્ય સંસ્થા (WHO)ના રેફરન્સ એન્ડ રિસર્ચ ઓન ફંગી ઓફ મેડિકલ ઇમ્પોર્ટન્સના સહયોગી કેન્દ્ર પર મોકલ્યા છે. સંક્રમિત વ્યક્તિને ડાયાબિટીસ, HIV સંક્રમણ, કિડનીની બીમારી કે પછી કોઈ બીજા પ્રકારની જૂની બીમારી નહોતી. દુનિયામાં છોડથી માણસમાં થયેલા પોતાની જાતના સંક્રમણના કેસના કારણે ચોડ્રોસ્ટેરિયમ પરપ્યૂરિયમ બતાવવામાં આવી રહ્યો છે.
આ એક ફૂગનો છોડ હોય છે, જેના કારણે છોડમાં સિલ્વર લીફ રોગ હોય છે. આ છોડ ગુલાબ પરિવારનો હોય છે. જો કે, અત્યાર સુધી આ છોડના કારણે માણસમાં સંક્રમણ થવાનો કેસ જોવા મળ્યો નહોતો. માણસમાં રોગ ઉત્પન્ન કરનાર છોડના ફૂગનો આ પહેલો કેસ છે. રિસર્ચર્સ બતાવે છે કે સંક્રમિત વ્યક્તિની સારવાર માટે તેને એન્ટી ફંગલ દવાઓ આપવામાં આવી, જેથી તે પૂરી રીતે સારો થઈ ચૂક્યો છે. 2 વર્ષના ફોલોઅપ બાદ હવે પૂરી રીતે સ્વાસ્થ્ય છે અને તેના ફરીથી સંક્રમિત થવાના પુરાવા મળ્યા નથી.

